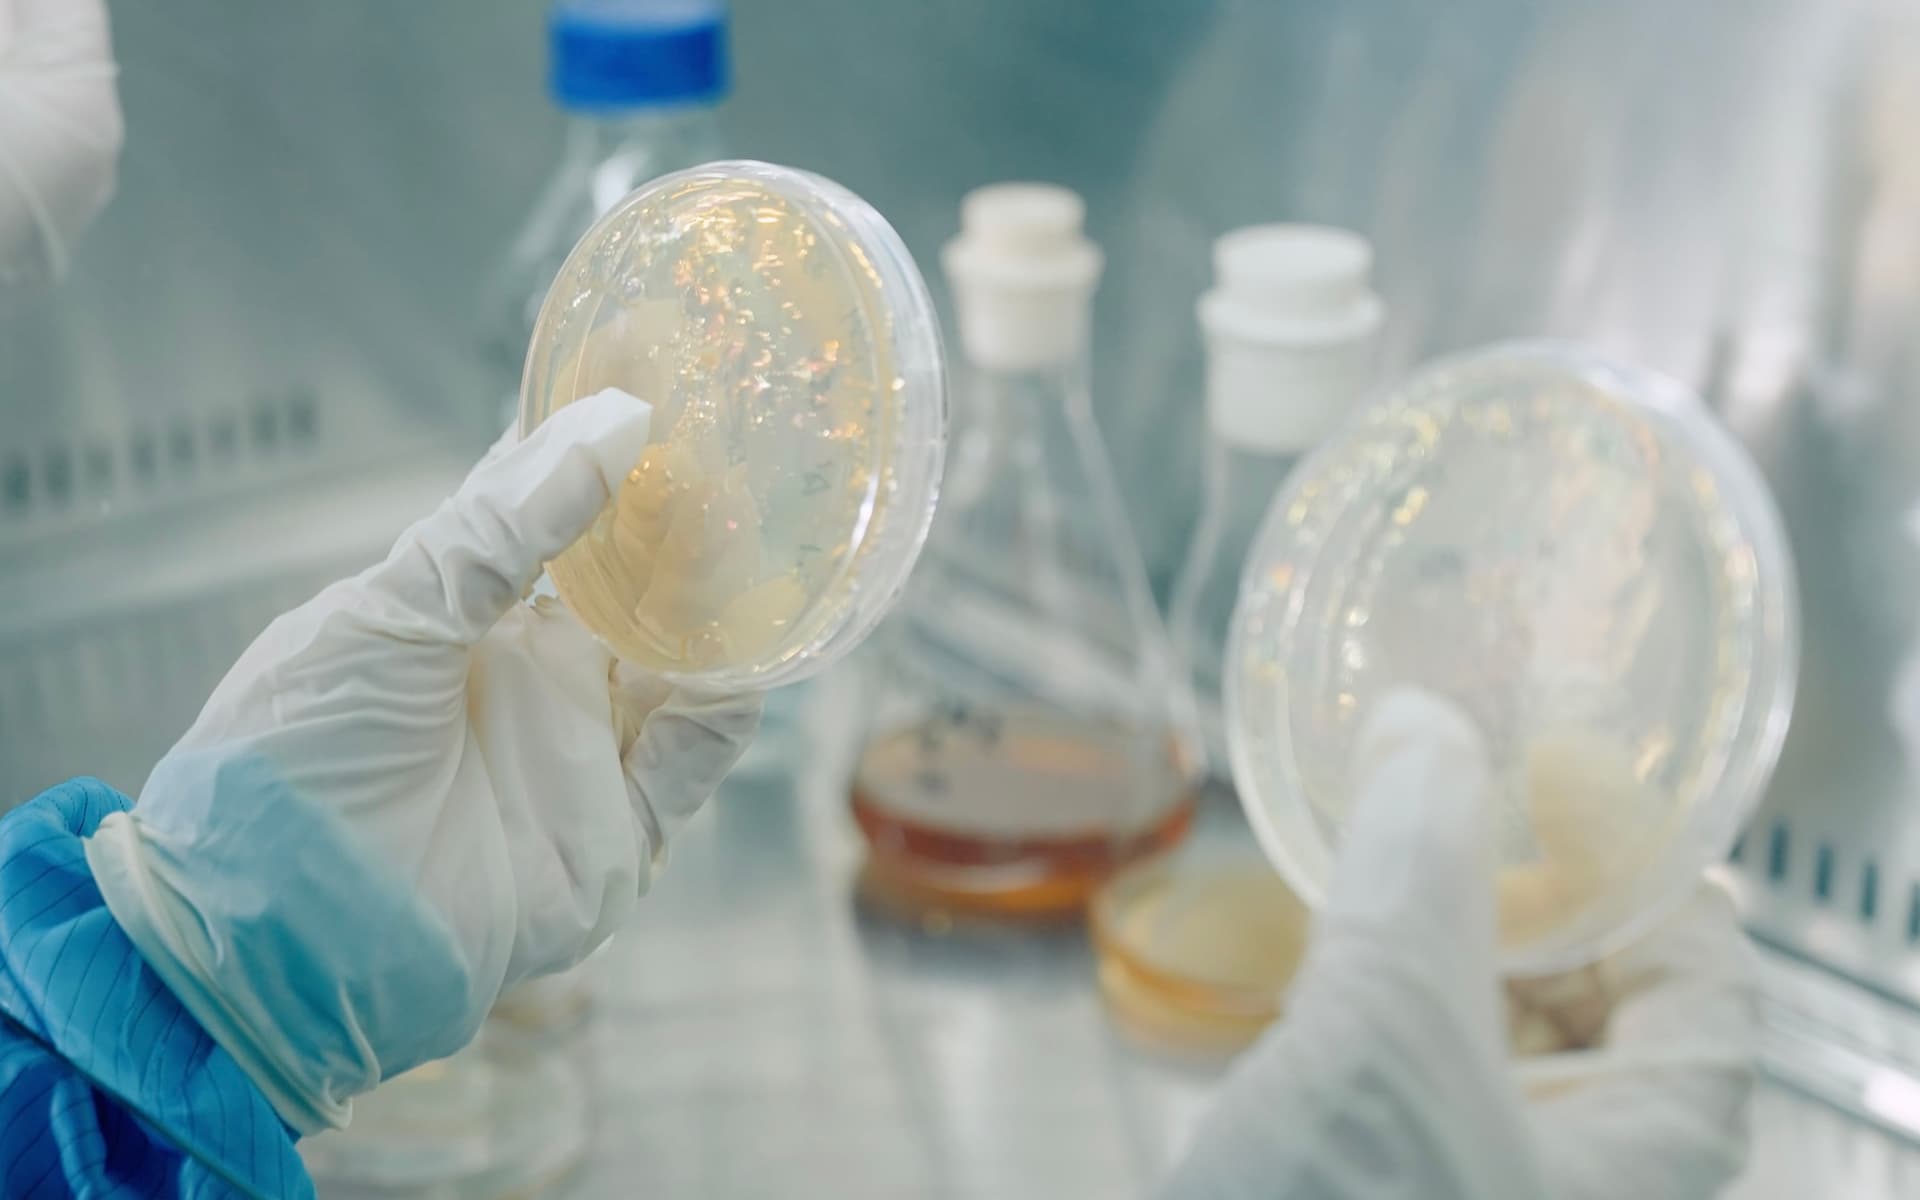
BONNEHEURE znanstveno utemeljeni razvoj kolagena

Kolagen koji se nadovezuje na tvoju kožu, kao da je uvijek bio dio nje.
Rekombinanti Humani kolagen Tipa III proizveden je u laboratoriju uz pomoć visoke biotehnologije i specijalnih kvasaca. Integracijom kodona u plazmid, dobivamo kolagen podudaran čovjeku u strogo kontroliranim uvjetima. Fermentacijom se stvara kolagen tipa III neprekinutog niza od 1068 aminokiselina koje tvoja koža prirodno proizvodi procesom zvanim kolageneza.
Najnapredniji kolagen
Naš kolagen, trenutno u svijetu ima jednu od najviše moguće biološke podudarnosti s ljudskim.
U simbiozi s kožom
Ugrađuje se u tvoju kožnu strukturu, potiče obnavljanje kožne barijere i vraća elastičnost.